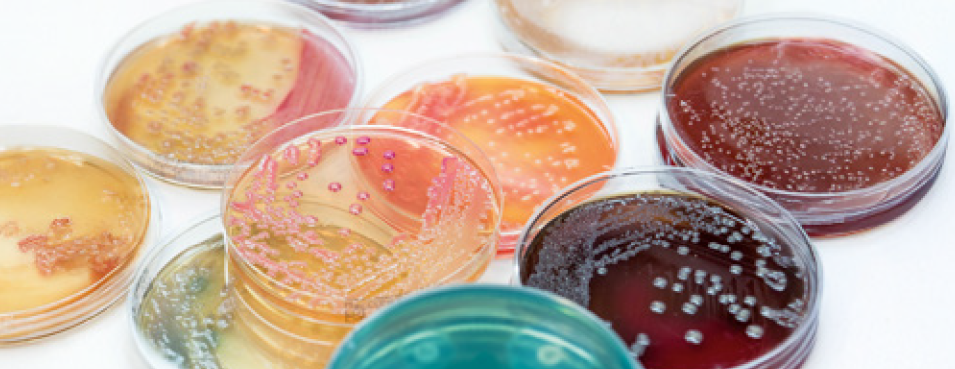
Mikrobiologie - Der andere Laborauftrag 2026

Ihr Warenkorb ist leer

MVZ Labor Dr. Reising-Ackermann und Kollegen
Seit Gründung im Jahre 1990 entwickelten sich unsere Laboratorien zu einem leistungsfähigen und modernen Unternehmen. Heute arbeiten mehr als 300 Mitarbeiter, davon 27 Ärzte und 40 weitere Akademiker an zehn Standorten in Sachsen.
Als medizinisch diagnostisches Labor stehen wir für mehr als 1.000 niedergelassene Ärzte und 40 Kliniken mit einem umfangreichen Leistungsportfolio täglich 24 Stunden zur Verfügung. Mit exzellenten Fachleuten, engagierten Mitarbeitern und modernster Technik setzen wir Standards in der Laboratoriumsmedizin, Mikrobiologie und Hygiene. Gleichzeitig verfügen unsere Ärzte über langjährige Erfahrung in der Transfusionsmedizin, Humangenetik, Hämostaseologie, Pathologie und Zytologie.
Unsere Laboratorien sind nach DIN EN ISO 15189 und DIN EN ISO 17025 akkreditiert und verfügen über Weiterbildungsermächtigungen der Sächsischen Landesärztekammer für Laboratoriumsmedizin, Mikrobiologie und Infektionsepidemiologie, Transfusionsmedizin und Hämostaseologie.
Wir garantieren Ihnen schnellstmögliche zuverlässige Ergebnisse, individuelle Befundinterpretationen und konkrete Therapieempfehlungen – Kompetenz aus einer Hand.
Wir freuen uns auf die Zusammenarbeit mit Ihnen.
Als medizinisch diagnostisches Labor stehen wir für mehr als 1.000 niedergelassene Ärzte und 40 Kliniken mit einem umfangreichen Leistungsportfolio täglich 24 Stunden zur Verfügung. Mit exzellenten Fachleuten, engagierten Mitarbeitern und modernster Technik setzen wir Standards in der Laboratoriumsmedizin, Mikrobiologie und Hygiene. Gleichzeitig verfügen unsere Ärzte über langjährige Erfahrung in der Transfusionsmedizin, Humangenetik, Hämostaseologie, Pathologie und Zytologie.
Unsere Laboratorien sind nach DIN EN ISO 15189 und DIN EN ISO 17025 akkreditiert und verfügen über Weiterbildungsermächtigungen der Sächsischen Landesärztekammer für Laboratoriumsmedizin, Mikrobiologie und Infektionsepidemiologie, Transfusionsmedizin und Hämostaseologie.
Wir garantieren Ihnen schnellstmögliche zuverlässige Ergebnisse, individuelle Befundinterpretationen und konkrete Therapieempfehlungen – Kompetenz aus einer Hand.
Wir freuen uns auf die Zusammenarbeit mit Ihnen.
Notfall in der Arztpraxis 2. Termin 2026
3:00 Std.
04.11.2026 | 15:00
35,00 €
Deeskalationsmanagement 2026
3:00 Std.
07.10.2026 | 15:00
35,00 €
Tipps und Tricks bei der Blutentnahme 2. Termin 2026
2:00 Std.
23.09.2026 | 15:00
Kostenfrei
Mikrobiologie - Der andere Laborauftrag 2026
3:00 Std.
02.09.2026 | 15:00
Kostenfrei
13. Allergiesymposium 2026
3:30 Std.
10.06.2026 | 16:00
35,00 €